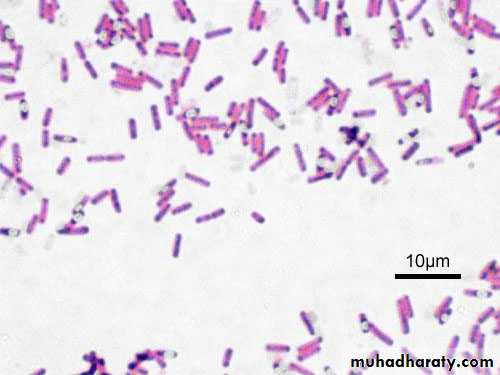
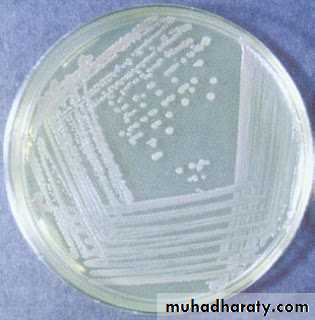
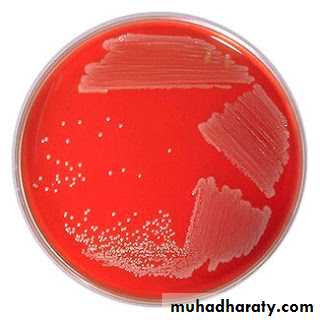
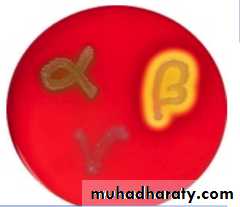
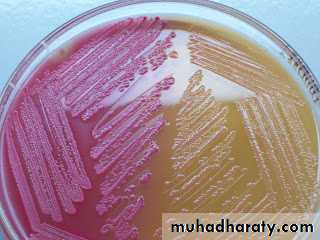
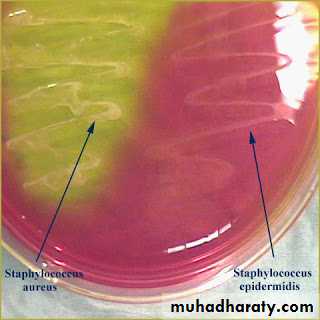

Differential stains
Gram stainGram staining is the single most useful test in the clinical microbiology laboratory. It is the differential staining procedure most commonly used for the direct examination of specimens and bacterial colonies because it has a broad staining spectrum. The Gram stain is the first differential test run on a bacterial specimen brought into the laboratory for specific identification. The staining spectrum includes almost all bacteria, many fungi, and parasites such as Trichomonas, Strongyloides, and miscellaneous protozoan cysts. The significant exceptions include Treponema, Mycoplasma, Chlamydia, and Rickettsia, which are too small to visualize by light microscopy or lack a cell wall. Gram stains are performed on body fluid or biopsy when infection is suspected. Gram stains yield results much more quickly than culturing, and is especially important when infection would make an important difference in the patient's treatment and prognosis; examples are cerebrospinal fluid for meningitis and synovial fluid for septic arthritis.
The Gram stain is a differential stain commonly used in the microbiology laboratory that differentiates bacteria on the basis of their cell wall structure. Most bacteria can be divided into two groups based on the composition of their cell wall:
This differential staining procedure separates most bacteria into two groups on the basis of cell wall composition:
Gram positive bacteria (thick layer of peptidoglycan-90% of cell wall)- stains purple
Gram negative bacteria (thin layer of peptidoglycan-10% of cell wall and high lipid content) –stains red/pink
Cell wall of Gram Positive and Gram Negative Bacteria
Principle of Gram Stain:In aqueous solutions crystal violet dissociates into CV+ and Cl – ions that penetrate through the wall and membrane of both gram-positive and gram-negative cells. The CV+ interacts with negatively charged components of bacterial cells, staining the cells purple.
When added, iodine interacts with CV+ to form large Crystal violet iodine (CV-I) complexes within the cytoplasm and outer layers of the cell
The decolorizing agent, (ethanol or an ethanol and acetone solution), interacts with the lipids of the membranes of both gram-positive and gram-negative Bacteria.The outer membrane of the gram-negative cell (lipopolysaccharide layer) is lost from the cell, leaving the peptidoglycan layer exposed. Gram-negative cells have thin layers of peptidoglycan, one to three layers deep with a slightly different structure than the peptidoglycan of gram-positive cells . The highly cross-linked and multi-layered peptidoglycan of the gram-positive cell is dehydrated by the addition of ethanol. The multi-layered nature of the peptidoglycan along with the dehydration from the ethanol treatment traps the large CV-I complexes within the cell. With ethanol treatment, gram-negative cell walls become leaky and allow the large CV-I complexes to be washed from the cell.
After decolorization, the gram-positive cell remains purple in color, whereas the gram-negative cell loses the purple color and is only revealed when the counterstain, the positively charged dye safranin, is added.
Nearly all clinically important bacteria can be detected using Gram staining method the only exceptions being those organisms;
1.That exists almost exclusively within host cells i.e. Intracellular bacteria (e.g., Chlamydia)
2.Those that lack a cell wall (e.g., Mycoplasma)
3.Those of insufficient dimensions to be resolved by light microscopy (e.g., Spirochetes)
Gram variable & Gram-indeterminate bacteria:
Some bacteria, after staining with the Gram stain, yield a gram-variable pattern: a mix of pink and purple cells are seen.The genera, Corynebacterium, Mycobacterium, and Propionibacterium have cell walls particularly sensitive to breakage during cell division, resulting in gram-negative staining of these gram-positive In additionthe age of the culture may influence the results of the stain.[citation needed]. Dead Gram positive bacteria may also stain Gram negative or Gram variable.
Gram-indeterminate bacteria do not respond predictably to Gram staining and, therefore, cannot be determined as either gram-positive or gram-negative; they tend to stain unevenly, appearing partially gram-positive and partially gram-negative, or unstained by either crystal violet or safranin.[citation needed] Examples include many species ofMycobacterium, including M. tuberculosis and M. leprae.[15][16]
Gram-indeterminate bacteria are best stained using acid-fast staining techniques.[citation needed] Staining older cultures (over 48 hours) can lead to false gram-variable results, probably due to changes in the cell wall with aging
Gram variable bacilli.
.
Procedure:
1. Prepare heat-fixed smears of E. coli, S. aureus, and the mixture of E. coli and S. aureus
2. Place the slides on the staining rack.
3. Flood the smears with crystal violet and let stand for 1 minute.
4. Rinse with water for 5 seconds
5. Cover with Gram’s iodine mordant and let stand for 1 minute
6. Rinse with water for 5 seconds
7. Decolorize with 95% ethanol for 15 to 30 seconds. Do not decolorize too long. Add the decolorizer drop by drop until the crystal violet fails to wash from the slide
8. Rinse with water for 5 seconds
9. Counterstain with safranin for about 60 to 80 seconds
10. Rinse with water for 5 seconds
11. Blot dry with bibulous paper and examine under oil immersion. Gram-positive organisms stain blue to purple ( example :Staphylococcus aureus) ; gram-negative organisms stain pink to red ( example Escherichia coli). There is no need to place a coverslip on the stained smear.
Gram staining reactions ; Gram negative and Gram positive
NOTE: Indistinct Gram-stain results can be confirmed by a simple test using KOH. Place a drop of 10% KOH on a clean glass slide and mix with a loopful of bacterial paste. Wait 30 seconds, then pull the loop slowly through the suspension and up and away from the slide. A gram-negative organism will produce a mucoid string; a gram-positive organism remains fluid.In order to get accurate results:
a.use young cultures of bacteria -24 hours old or younger.b.prepare smears that are not thick.
c.do not over heat your slide when you fix the bacteria.
d. use fresh reagents.
e.do not leave excess water on the slide between stains
Culture media
A culture medium is defined as a solid or liquid preparation used for the growth, transport, and storage of microorganisms. The effective culture medium must contain all the nutrients required for the growth of the microorganism. all microorganisms need sources of energy, nitrogen, carbon, phosphorus, sulfur, and various minerals,One of the most important reasons for culturing bacteria in vitro is its utility in diagnosing infectious diseases. Isolating a bacterium from sites in body normally known to be sterile is an indication of its role in the disease process. Culturing bacteria is also the initial step in studying its morphology and its identification. Bacteria have to be cultured in order to obtain antigens from developing serological assays or vaccines. Certain genetic studies and manipulations of the cells also need that bacteria be cultured in vitro. Culturing bacteria also provide a reliable way estimating their numbers (viable count). Culturing on solid media is another convenient way of separating bacteria in mixtures.
Classification Of Culture media based on consistency
Solid mediumsolid medium contains agar at a concentration of (1.5-2.0%) Solid medium has physical structure and allows bacteria to grow in physically informative or useful ways (e.g. as colonies or in streaks). Solid medium is useful for isolating bacteria or for determining the colony characteristics of the isolate.Semisolid mediaThey are prepared with agar at concentrations of 0.5% or less. They have soft custard like consistency and are useful for the cultivation of microaerophilic bacteria or for determination of bacterial motility.
Liquid (Broth) mediumThese media contains specific amounts of nutrients but without solidifying agents . Broth medium serves various purposes such as propagation of large number of organisms, fermentation studies, and various other tests. eg. sugar fermentation tests.
Solidifying Agents : Any liquid medium can be rendered solid by the addition of certain solidifying agents .
Before the use of agar, attempts were made to use gelatin as solidifying agent. Gelatin had some inherent problems:It changed from a solid to a liquid at about 25 degrees C., preventing it from being incubated at 37ᵒC.,which is optimal for most bacteria. Gelatin is liquefied by the enzyme gelatinase, which is produced by most proteolytic bacteria. Agar is a more common solidifying agent for a culture medium characterized y being a seaweed extract (polysaccharide), melts at 100°C, solidifies at 40°C, held at 50°C for plating usually poured at 45°C. Most bacteria can’t degrade agar.Also, it is useful for isolating individual colonies to establish pure cultures and looking at some biochemical properties of the cultures.
Classification based on the basis of purpose/ functional use/ application Many special purpose media are needed to facilitate recognition, enumeration, and isolation of certain types of bacteria. To meet these needs, numerous media are available.
General purpose media/ Basic mediaBasal media are basically simple media that supports most non-fastidious bacteria. Peptone water, nutrient broth and nutrient agar are considered as basal medium. Nutrient Agar
These media are generally used for the primary isolation of microorganisms.
B. Enriched medium (Added growth factors):
Blood agar
Addition of extra nutrients in the form of blood, serum, egg yolk etc, to basal medium makes them enriched media. Enriched media are used to grow nutritionally exacting (fastidious) bacteria. Blood agar, (also used to detect hemolytic activity of bacteria), chocolate agar, Loeffler’s serum slope etc are few of the enriched media. Blood agar is prepared by adding 5-10% (by volume) to a blood agar base. Chocolate agar is also known as heated blood agar or lysed blood agar. According to hemolytic activity of bacteria, there are three types of hemolysis: Certain bacteria produce enzymes (hemolysins…) that act on the red cells to produce either:Beta hemolysis: Enzymes lyse the blood cells completely, producing a clear area around the colony. Ex: S. aureus
Alpha hemolysis: Incomplete hemolysis produces a greenish discoloration around the colony Ex: Streptococcus pneumoniae
Gamma hemolysis: No effect on the red cells. Ex: S. epidermidis
C.Selective media
This is a type of medium in which an inhibitory substance is added to favor the growth of a particular bacteria of interest while inhibiting the growth of other unwanted bacteria. Inhibitory substance may be dyes, bile salts, alcohol, acids and antibiotics. These medium are used to isolate a particular bacteria from a specimen expected to have mixed bacterial flora. .
Examples of selective media include:
Thayer Martin Agar used to recover N.gonorrhoeae contains Vancomycin, Colistin and Nystatin.
Mannitol Salt Agar and Salt Milk Agar used to recover S.aureus contain 10% NaCl.
Potassium tellurite medium used to recover C.diphtheriae contains 0.04% Potassium tellurite.
MacConkey’s Agar used for Enterobacteriaceae members contains Bile salt that inhibits most gram positive bacteria.
Pseudosel Agar (Cetrimide Agar) used to recover P.aeruginosa contains cetrimide (antiseptic agent).
Crystal Violet Blood Agar used to recover S.pyogenes contains 0.0002% crystal violet.
Lowenstein Jensen Medium used to recover M.tuberculosis is made selective by incorporating malachite green. Figure( ): MacConkey agar
Wilson and Blair’s Agar for recovering S.typhi is rendered selective by the addition of dye brilliant green.
Selective media such as TCBS Agar used for isolating V. cholerae from fecal specimens have elevated pH (8.5-8.6), which inhibits most other bacteria.
4. Differential medium: Certain media are designed in such a way that different bacteria can be recognized on the basis of their colony colour. Various approaches include incorporation of dyes, metabolic substrates etc, so that those bacteria that utilize them appear as differently coloured colonies. Such media are called differential media or indicator media. Differential media allow the growth of more than one microorganism of interest but with morphologically distinguishable colonies.
Examples of differential media include:
Figure ( ): Mannitol Salt Agar
Mannitol salts agar (mannitol fermentation = yellow)
Blood agar (various kinds of hemolysis i.e. α, β and γ hemolysis)Mac Conkey agar (lactose fermenters, Pink colonies whereas non- lactose fermenter produces pale or colorless colonies.
TCBS (Vibrio cholera produces yellow colonies due to fermentation of sucrose)
5. Transport media:Clinical specimens must be transported to the laboratory immediately after collection to prevent overgrowth of contaminating organisms or commensals. This can be achieved by using transport media. Such media prevent drying (desiccation) of specimen, maintain the pathogen to commensal ratio and inhibit overgrowth of unwanted bacteria. Some of these media (Stuart’s & Amie’s) are semi-solid in consistency. Addition of charcoal serves to neutralize inhibitory factors.
6. Anaerobic media:Anaerobic bacteria need special media for growth because they need low oxygen content, reduced oxidation –reduction potential and extra nutrients.
Media for anaerobes may have to be supplemented with nutrients like hemin and vitamin K. Such media may also have to be reduced by physical or chemical means. Boiling the medium serves to expel any dissolved oxygen. Addition of 1% glucose, 0.1% thioglycollate, 0.1% ascorbic acid, 0.05% cysteine or red hot iron filings can render a medium reduced. Before use the medium must be boiled in water bath to expel any dissolved oxygen and then sealed with sterile liquid paraffin.